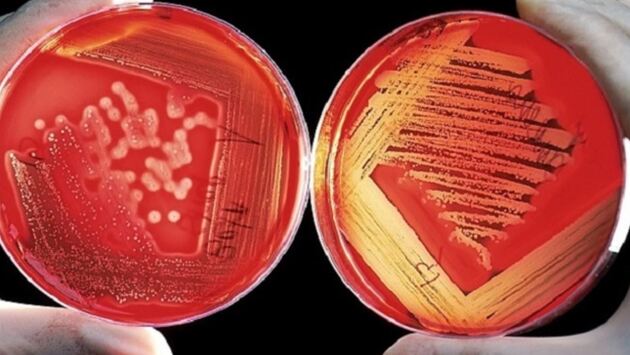

В РФ создан новый метод диагностики сердечно-сосудистых заболеваний
В случае бессимптомного атеросклероза именно сосуды становятся «мишенью» — нарушение их целостности и функций приводят к тяжелым заболеваниям, включая инфаркт миокарда. Причем в последнее время закрепилась неприятная тенденция: атеросклероз всё чаще поражает молодых, 30 - 40-летних людей.
О новом методе, с помощью которого проверить сосуды может каждый, сообщили в Минобрнауки. Новый способ состоит из биохимического анализа крови с определением общего холестерина, триглицеридов и липопротеидов низкой плотности, а также УЗИ общих сонных артерий. Каждый выходящий за пределы нормы показатель получает 1 балл. Кроме того, дополнительный балл начисляется мужчинам. У пациентов, набравших от 5 баллов и выше, констатируется высокий риск коронарного атеросклероза, даже если в данный момент нет никаких симптомов.
Разработанный подход испытали на 198 добровольцах с разными формами ишемической болезни сердца и 57 здоровых людях. Результаты подтвердили, что метод позволяет надежно диагностировать ишемическую болезнь.